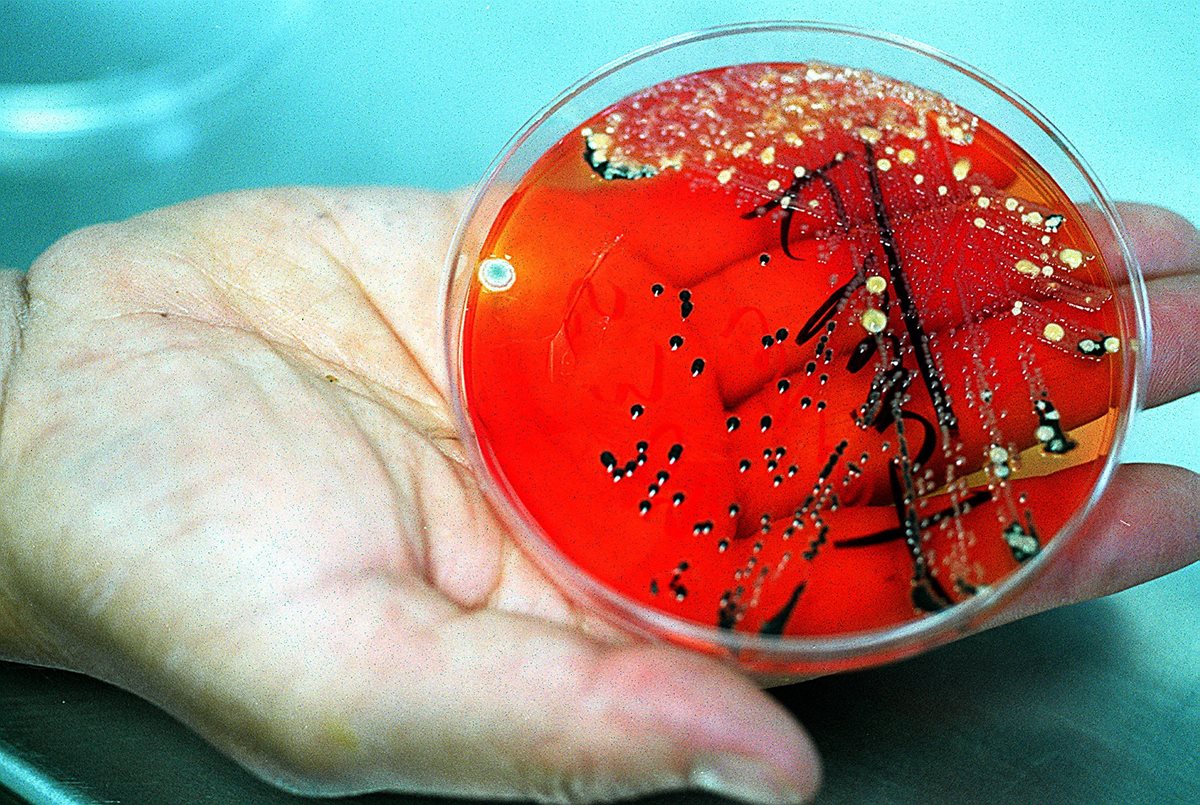
Image

11 de septiembre de 2018 - 8:53h
Toallas desechables vs. secadores de aire: ¿qué forma se de secarse las manos es la más saludable?
6 de abril de 2018 - 20:39h
Bacterias pueden estar vinculadas con la obesidad infanti

22 de febrero de 2017 - 13:39h
Las espectaculares cuevas de México que albergan microbios de más de 10.000 años (y que lograron resucitar)
9 de febrero de 2017 - 17:52h
Un estudio señala que los desinfectantes no eliminan bacterias en hospitales

2 de enero de 2017 - 13:07h
Por qué tienes que lavar tu toalla de baño mucho más seguido de lo que piensas

11 de noviembre de 2016 - 11:08h
Frágiles, amarillentas o con manchas blancas: cuáles son las anomalías y problemas más frecuentes de las uñas
26 de mayo de 2016 - 16:53h









